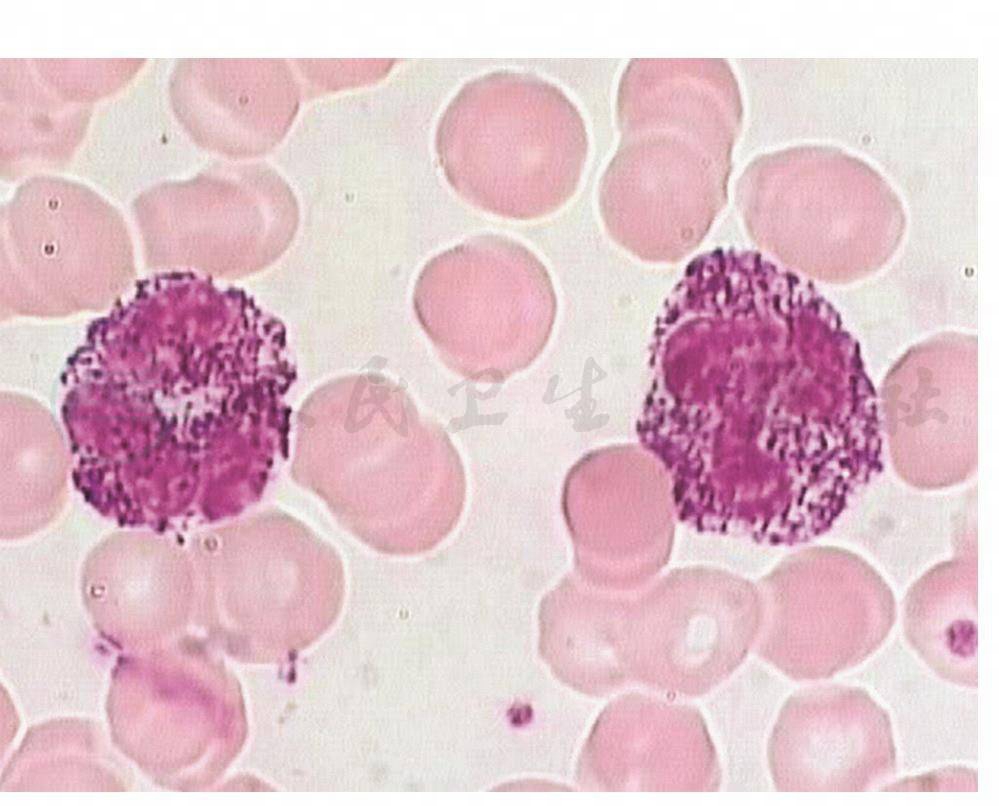
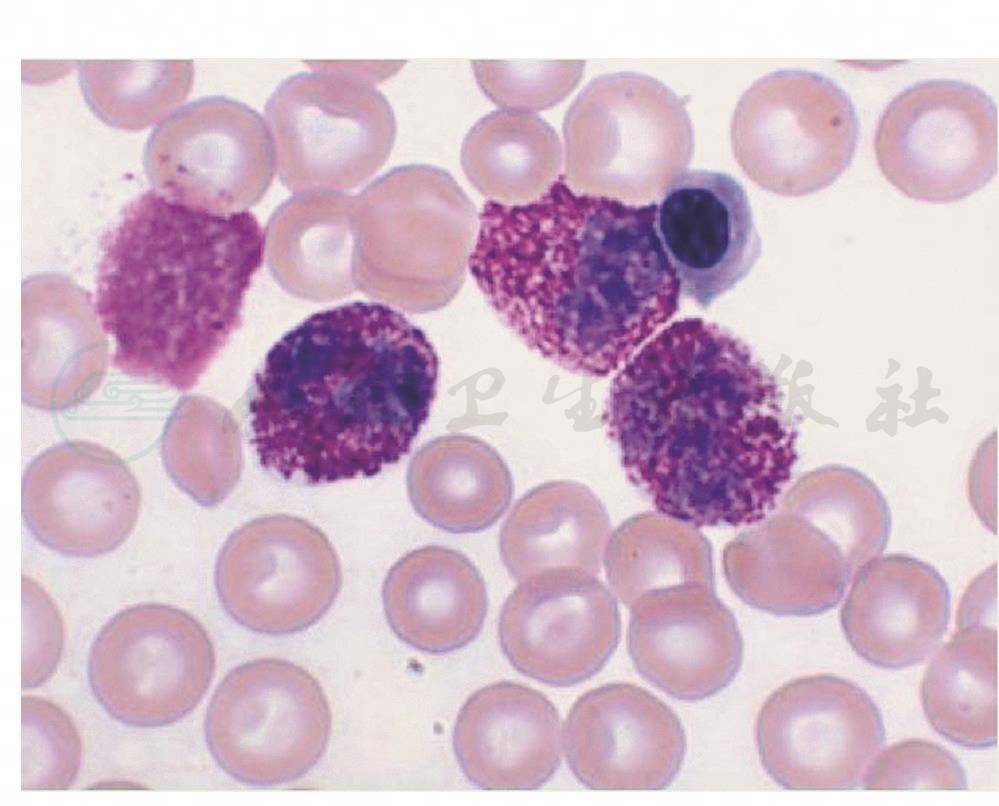

基本信息
中文别名 :黏多糖性血细胞异常
作者
郑杰
概述
1939年Alder描述了一种致密的、明显的、较大的嗜天青颗粒,见于所有的白细胞(图33-4)(Alder,1939)。中性粒细胞中,这种颗粒可能类似于中毒颗粒,但它与感染无关,也不是暂时存在的。1941年,Reilly描述了类似的颗粒,见于部分患者但不限于脂肪软骨营养不良症、Hurler综合征,或更为普遍的遗传性黏多糖沉积症(Reilly,1941)。其他研究发现,中性粒细胞的大颗粒可作为遗传性黏多糖沉积症的特征出现,或在其他健康人群中独立存在(Brunning,1970)。
遗传性黏多糖沉积症中,比Alder-Reilly异常更为常见的是淋巴细胞中的异染包含体,这些淋巴细胞(的颗粒)周围环绕着光晕。骨髓中的巨噬细胞经常含有类似的颗粒。这是一种遗传性疾病,其特征为降解黏多糖所需的各种溶酶体酶不足或紊乱,导致多器官黏多糖的异常沉积和贮存。最为明显的是骨骼异常。
解剖学与组织学
中性粒细胞中含有巨大深染的嗜天青颗粒,染深紫色。该颗粒与中毒颗粒的区别是颗粒较大,不伴有白细胞数量增高、核左移和空泡变性等毒性改变(图1、2)。
图1Alder-Reilly畸形
引自:血象——外周血细胞图谱.第1版.ISBN:978-7-117-23323-1.主编:
图2Alder-Reilly畸形
引自:血象——外周血细胞图谱.第1版.ISBN:978-7-117-23323-1.主编:
此内容为收费内容
来源
血象:外周血细胞图谱,第1版,978-7-117-23323-1,2016.12



